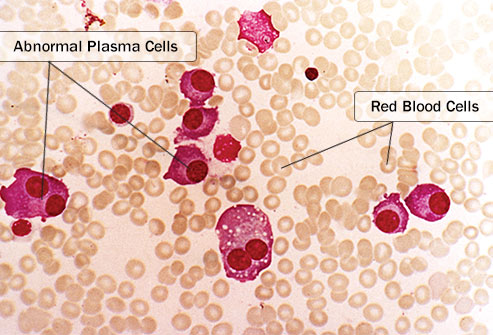

سلولهای پلاسما آنتی بادی ها را می سازند، که با میکروب ها مبارزه میکنند. اگر شما سرماخوردگی بگیرید، آنها می توانند یک آنتی بادی برای حمله به ویروسی که موجب مریضی شما شده است، تولید کنند. سلول های پلاسما غیر طبیعی، به این صورت کار نمی کنند. سلول های میلوم افزایش می یابند و به سرعت سلولهای پلاسما سالم شما را که همراه با دیگر سلول های سفید خون از شما در برابر عفونت محافظت می کنند، پس میزنند.